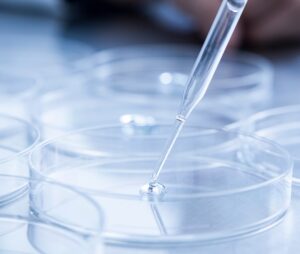

ー NEWS ー

幹細胞培養上清液の力を医療、美容へ
幹細胞培養上清液の特性にいち早く注目し、クリニック様だけではなく、エステ、まつエクなどの美容サロン様への出荷、また化粧品の原材料としてのご提供などさまざまな用途でご活用いただいてまいりました。
また、自社ブランドの製品製造などのご要望にも柔軟に対応致します。
より医療に近いメディカルエステのご提案
リライフメディカルがご提案するメディカルエステ「RMCシステム」は再生医療の発想を取り入れた最新のエステシステムです。自社培養の高純度・高濃度の幹細胞培養上清液を痛みやダウンタイムのない針なし注射・近赤外線・音響振動で従来のエステでは叶わなかった真皮層まで導入することが可能になっています。さらに幹細胞培養上清液と合わせて導入する美容液剤はお悩みに合わせてセレクト可能なのでお客様のお悩みや肌質に合わせた施術が可能です。



クリニックも運営
福岡市中央区に再生医療・美容皮膚科のクリニックを運営しています
点滴・水光注射・HIFU・メディカルエステ等行っています